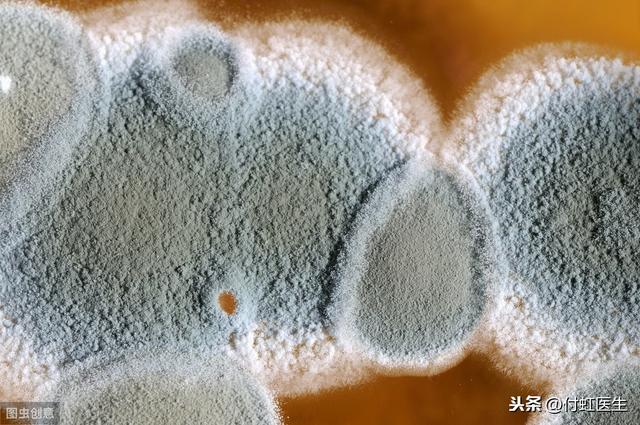
#健康真相馆#5岁小女孩得了阴道炎，病因值得所有妈妈深思

微信扫码关注
微信扫码关注看新鲜资讯

 微信扫码关注
微信扫码关注妇科门诊,我正在为一个病人写病历,一个中年女子慌张破门而入,她的怀里抱着一个四五岁哇哇哭的小女孩,“医生,我孩子屁屁不舒服,您这里能看吗?”

“好的。我给这位女士写完病历就给您的孩子看看,您挂号了吗?”我问道。
“嗯,医生我挂号了,下一个就是我们宝宝,太着急了才抱孩子进来先问问,害怕看不了还要去别的医院。”中年女子解释道。
轮到给这位女宝宝看病,我还是先询问了宝宝有什么不舒服?
“医生阿姨,您同意不给我打针我就告诉您。”小女孩不哭了,大眼睛一眨一眨的很可爱。
“你先说说哪里不舒服了,能不打针就不打针。”我温柔的保证。
“医生,我的玲珑宝宝太乖了,她肯定是在幼儿园里被淘气小子欺负了,这两天一直说屁屁疼,晚上我给她清洗的时候居然看到了白带,还是臭味的,您说说这是怎么回事?”小女孩还没说话,她的妈妈先说了。

“医生阿姨,不是我妈妈说的那样,幼儿园里有老师,男生们都很听话,没有人欺负我。”小女孩辩解道。
“谁说的,上周你不是还说有一天中午在幼儿园吃午饭,一个小男生平白无故的把你推倒了吗?老师都没发现,你也不告诉老师,还不告诉妈妈是哪个小男生把你推倒了,要是知道是谁,妈妈可饶不了他!”妈妈继续说道。
“妈妈,上周的事情我不是说了吗?那个男生吃着东西走路,才不小心撞到我了,人家都都说对不起了,我才没告诉老师。”小女孩的脸红了。
“那现在是怎么回事?是不是哪个坏小子摸你的屁屁了?那就是耍流氓,我必须告诉老师,你快告诉我是谁?”
“妈妈,根本没有小男生摸我的屁屁,就是我我……”小女孩的脸更红了,已经说不出话来。
“医生,对了,你还要看看我女儿的处女膜完整不?”中年女子着急的说。
安排女子给女儿脱掉裤子和内裤,并抱到换好检查垫的妇科检查床上,给玲珑检查后我发现,她的外阴和阴道粘膜充血、红肿,外阴的皮肤有抓痕,附着白色粘稠的分泌物,有异味。用棉签蘸取适量的分泌物送化验,结果提示: 霉菌性阴道炎 。

“医生医生,我女儿的处女膜完整吗?”中年女子着急的问。
“这位家长您放心,您女儿的处女膜目前看是完整的,没有被侵犯的痕迹,如果您女儿说的都是实话,请您相信她的话,不要疑神疑鬼。”我解释道。
“可是医生,这阴道炎都是已婚妇女得的病,孩子这么小,为啥会得这种妇科病?”虽然松了一口气,女子还是有疑问。
经过仔细询问玲珑的生活习惯,我找到了原因。
玲珑的妈妈1周前刚刚得了霉菌性阴道炎 ,而因为着急,有的时候玲珑的内裤和妈妈的内衣裤放在一个盆里一同清洗。加上夏天闷热潮湿,为了图省事,玲珑妈妈就在卫生间里晾晒内裤。
而霉菌性阴道炎本就夏季高发,霉菌偏爱潮湿闷热的环境。
婴幼儿阴道炎常见于5岁以下儿童,多合并外阴炎,临床表现主要为白带增多伴外阴瘙痒,局部红肿等。大量白带刺激引起外阴痛痒,女宝宝哭闹、烦躁不安或用手搔抓娇气的外阴。部分患儿伴有下泌尿道感染,出现尿急、尿频、尿痛的表现。
作为女宝宝的妈妈,要细心观察女儿的上述细微变化,及时带宝宝就医。
宝宝阴道炎的病因有哪些?
1.婴幼儿女宝宝的特点为外阴发育差,不能遮盖尿道口及阴道前庭,细菌容易趁虚而入。
2.与成人女子不同,女宝宝出生后2~3周,母体来源的雌激素水平下降,雌激素水平低的结果就是阴道上皮缺乏营养而变薄,pH升至6~8,阴道环境中维持健康的乳杆菌变成非优势菌,导致抵抗力低下的阴道易受其他细菌感染。
3.女宝宝卫生习惯不佳,外阴不洁、大便污染、外阴损伤或饶虫感染,均可引起严重感染。

4.好奇的女宝宝在阴道内放置橡皮、铅笔头、纽扣等异物,导致继发感染。
5. 患有足癣或霉菌阴道炎的家长将自己的衣物与女童的衣裤一起清洗,就容易导致女宝的霉菌性阴道炎的发生。

6.病原体也可通过患病母亲或保育员、幼儿园老师的手、衣物、毛巾、浴盆等间接传染给女宝宝。
治疗就是给玲珑口服抗真菌的药物和阴道口处涂抹抗真菌的药膏。
用药后1周,玲珑妈妈再次带着女儿复查,身穿红色连衣裙的玲珑嘻嘻笑着,复查结果也是分泌物常规:II度,滴虫、霉菌(-)。结果正常。
对于婴幼儿外阴阴道炎 ,预防如下:

1、注意保持婴儿外阴清洁和干燥。小婴儿使用尿布,最好选择柔软、透气好的纯棉制品,少用或不用“尿不湿”;大小便后要及时更换尿布,每天坚持清洗外阴,擦洗时要注意自上而下擦拭干净尿道口、阴道口及肛门周围,并轻轻擦拭干净阴唇及皮肤皱褶处;皮肤如有皲裂,应涂擦无刺激性的油膏。
2、尽早穿封裆裤,尽量不让孩子在地板上坐卧;衣服要柔软、宽松、舒适,少穿或不穿紧身裤、高筒袜等。
3、要重视大小便后的清洁,特别是小便后,应用质量有保证的柔软的卫生巾擦拭尿道口及周围。注意小便的姿势,避免由前向后流入阴道。大便后应用清洁的卫生纸,由前方向后方擦拭,以免粪渣擦拭进阴道内。
4、婴幼儿的浴盆、毛巾等生活用品要固定,专人专用,避免与其他人或成人交叉感染。

把这篇文章转发给所有女宝宝的妈妈,呵护女性健康,从婴幼儿开始!

一键关注“付虹医生”,开启健康模式!
推荐阅读

❤️极品反差婊❤️中南大学林雁被同学捆绑捂嘴强奸,并威
❤️极品反差婊❤️中南大学林雁被同学捆绑捂嘴强奸,并威胁说:不乱动,敢动我就划破你的脸!
2026-03-08

清纯少女变成飞机杯!10人轮换开火车场面堪比缅北!小骚货
清纯少女变成飞机杯!10人轮换开火车!场面堪比缅北!小骚货都快被灌成泡芙了
2026-03-08

云南红河绿春县破瓦村哈尼族新婚人妻张者芬 大婚前夜惨遭曝
这位瓜友真不知道是该夸你还是该骂你了,云南红河绿春县破瓦村哈尼族新婚人妻 张者芬 大婚前夜被曝光了!可能不说她老公永远也不会知道自己的老婆原来是个实打实的顶级大骚货吧,经常与人约炮做爱,性瘾大性欲强几乎每
2026-03-08

江西师范学院「蒋琬莹」大学跟男友同居,文文静静的眼镜妹
江西师范学院「蒋琬莹」大学跟男友同居,文文静静的眼镜妹,反差性瘾这么大,边被插骚b,还自己拿个跳蛋搞逼才过瘾
2026-03-08

蜜桔美女主播【嬛嬛】和榜一大哥打炮 尿尿 自插 私拍福利视
蜜桔美女主播【嬛嬛】和榜一大哥打炮 尿尿 自插 私拍福利视频
2026-03-08